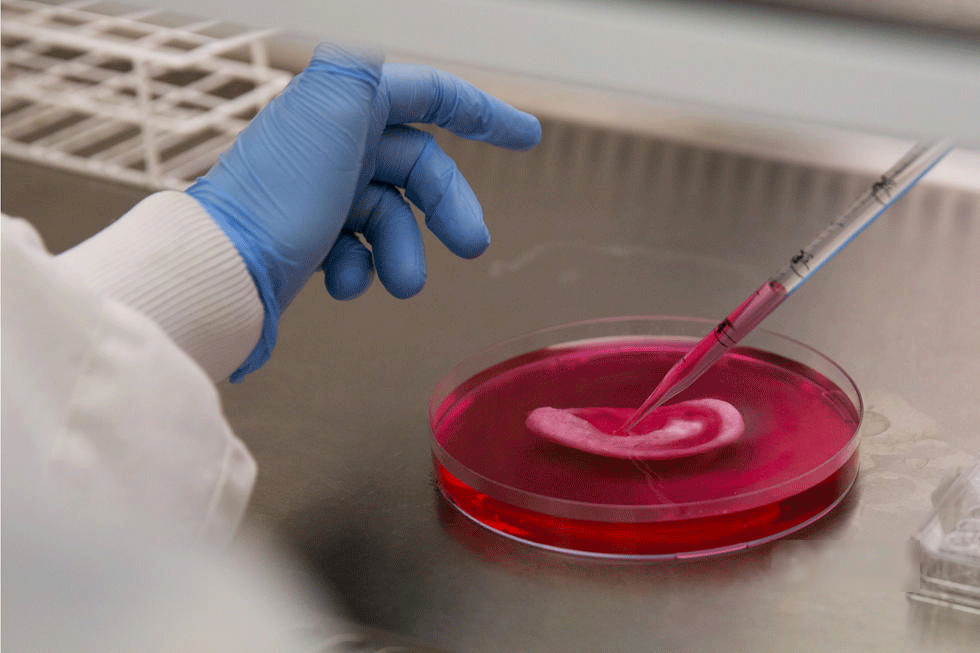
英国科学家通过干细胞培育人造器官(高清组图)

干细胞培养

今天以自体脂肪由来的间充质干细胞为例为大家说明干细胞培养的具体
图片尺寸600x636
人间充质干细胞无血清培养基汇总msc sfm 骨髓 脐带 脂肪
图片尺寸465x262
实验室培养细胞培养的科学家
图片尺寸700x467
干细胞培养回体内后,可以增加体内10亿个干细 胞,恢复30岁左右体内
图片尺寸671x382
【原创】我培养的骨髓间充质干细胞的图片
图片尺寸4000x3000
让自体干细胞能快速培养成功并做冻结保存
图片尺寸672x804
细胞培养的具体步骤和要求以及注意事项
图片尺寸818x570
脐带间充质干细胞的原代培养
图片尺寸1080x720
韩国新发现干细胞对过敏性鼻炎有抗变态反应作用
图片尺寸1600x1200
干细胞成骨诱导分化
图片尺寸5304x7952
首页 标签:"干细胞体外培养"(共找到约1条相关新闻)
图片尺寸830x829
干细胞_培养_图片素材
图片尺寸503x670
干细胞未来实验室的培养皿照片
图片尺寸388x300
干细胞技术登上人民日报疾病治疗前景可期
图片尺寸1035x691
包括干细胞外泌体技术,3d技术培养和器官组织再造等干细胞升级技术
图片尺寸1065x667
在体外培养诱导细胞增殖或/和分化,并通过移植所选的未分化的干细胞或
图片尺寸1000x618
英国科学家通过干细胞培育人造器官(高清组图)
图片尺寸980x653
【原创】我培养的骨髓间充质干细胞的图片
图片尺寸4000x3000
自体经血干细胞治疗卵巢功能问题日本东京神宫外苑
图片尺寸560x373
小胎盘蕴含大能量!干细胞存储是未来健康投资的最佳选择
图片尺寸999x667